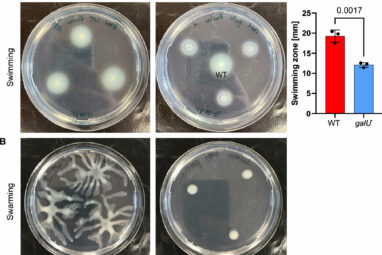

The end of the reproductive period, when flowers and fruits are produced, is a crucial moment in plants’ life cycles....
Smart vest turns fish into underwater spies, providing a glimpse into aquatic life like never before
Traditional techniques for observing fish behavior, largely dependent on vision-based systems, face substantial limitations, such as a confined range of...
Scientists have discovered a target for the development of a drug to combat a bacterium that can cause chronic lung...
In 1490, Leonardo da Vinci wrote, “If you cause your ship to stop and place the head of a long...
Several similar large, fossilized bone fragments have been discovered in various regions across Western and Central Europe since the 19th...
Cultural diversity is likely to have an overall positive effect on the biodiversity of ecosystems. The homogenization of human life...
New findings by Johns Hopkins University engineers working with a high-tech simulation of schooling mackerel, offer insight into why fish...
Some deeper areas of the Great Barrier Reef are insulated from harmful heat waves—but that protection will be lost if...
University of Michigan researchers have discovered that a worm commonly used in the study of biology uses a set of...
Since the 1970s, modern antibiotic discovery has been experiencing a lull. Now the World Health Organization has declared the antimicrobial...
Imagine switching on a light and being able to understand and control the inner dynamics of a cell. This is...
A team of researchers has uncovered alarming trends in the first range-wide genetic study of an endangered bee species. The...